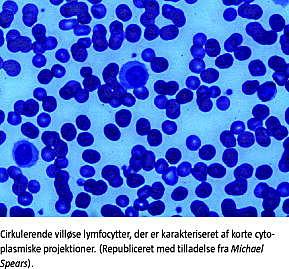

Splenisk marginalzonelymfom (SMZL) med eller uden villøse lymfocytter er et lavmalignt lymfom med beskrevet lang totaloverlevelsestid (overall survival (OS)). Behandlingen er ikke evidensbaseret, men baseret på retrospektive studier med ofte få patienter. Den traditionelle behandling til de behandlingskrævende patienter er splenektomi, men der kan desuden anvendes såvel kemoterapi, immunterapi med rituximab (både som monoterapi og i kombination med kemoterapi) som splenisk strålebehandling. Denne artikel omhandler det kliniske billede ved SMZL, og de afprøvede behandlinger beskrives.
Artiklen er baseret på en litteratursøgning i MEDLINE/PubMed i perioden fra september 2011 til december 2011. Inklusionskriterierne var, at artiklerne skulle være originalartikler med prospektive/retrospektive studier og kasuistikker, mens eksklusionskriterierne var ikkeengelsksprogede artikler. Der blev også brugt relevante artikler, der blev fundet i de udvalgte artiklers referencelister.
KLASSIFIKATION
SMZL er en sjælden subtype af non-Hodgkin-lymfom. Incidencen er ca.1% af alle lymfoide neoplasier [1, 2]. SMZL blev beskrevet første gang i 1987 af Melo et al [3] hos en gruppe på 22 patienter, der havde lavmalignt B-celle-lymfom, splenomegali og atypiske lymfocytter med villøse cytoplasmiske projektioner i perifert blod, hvorfor Melo et al betegnede det som splenisk lymfom med villøse lymfocytter (splenic lymphoma with villous lymphocytes (SLVL). Schmid et al [4] var den første, der anvendte begrebet splenisk marginalzonelymfom for at beskrive et lavmalignt lymfom hos fire patienter, hvis maligne celler havde den samme immunfænotype som de spleniske marginalzoneceller. Senere blev det påvist, at SLVL og SMZL er den samme sygdom, og SLVL betragtes nu som den leukæmiserede form af SMZL [5]. I WHO-klassifikationen fra 2008 er SMZL (med eller uden villøse lymfocytter) opført som en separat sygdom [5].
KLINISK BILLEDE OG PROGNOSE
Medianalderen ved debut er 68 år, og mand-kvinde-ratioen er 1:1,8 [1]. Det kliniske billede består som regel af splenomegali, knoglemarvsinfiltration, lymfocytose og/eller cytopeni [6-11]. I Tabel 1 opsummeres det kliniske billede af SMZL, sådan som det er beskrevet i forskellige studier. Lymfadenopati og B-symptomer er sjældne, men de spleniske hiluslymfeknuder kan ofte være involveret [1]. Hos ca. en tredjedel af patienterne kan der påvises en M-komponent - hyppigst immunglobulin M-κ - på diagnosetidspunktet, og hos 10-20% af patienterne ses der autoimmune fænomener, eksempelvis autoimmun hæmolytisk anæmi eller idiopatisk trombocytopenisk purpura. I det perifere blod er der ofte villøse lymfocytter, også i tilfælde med normalt lymfocyttal [6, 10]. De maligne celler er positive for CD19, CD20, CD79a og CD11c og er overvejende negative for CD5, CD10, CD23 og Cyklin-D1 [1, 6]. SMZL har diverse cytogenetiske forandringer, de hyppigste er trisomi 3q og deletion 7p, mens der sjældent ses t(11;18), som ofte ses ved maltomlymfomer [1, 5].
SMZL er at betragte som et lavmalignt lymfom med lang tid til progression og lang OS. Patienternes femårs-OS er estimeret til at være på 65-78% [6, 7], og den mediane OS er 8,5-13 år [7, 8]. Ca. 10% af SMZL transformerer til diffust storcellet B-celle-lymfom, hvilket medfører en markant dårligere prognose [8, 9].

BEHANDLING
Behandlingen af SMZL er empirisk. Ca. to tredjedele af patienterne er asymptomatiske ved diagnosetidspunktet, og hos ca. en tredjedel af dem bliver tilstanden aldrig behandlingskrævende [1]. Det er alment anerkendt, at man hos patienter uden symptomer anvender wait and watch -stategien, ligesom man gør ved andre lavmaligne lymfomer. Symptomatisk splenomegali med hypersplenisme (cytopenier), stigende lymfocyttal og symptomer på hypermetabolisme kan være indikationer på, at behandling bør initieres [6]. Den bedste behandling af patienterne med symptomer er dog stadig ikke fastlagt.
Splenektomi
Splenektomi har typisk været førstelinjebehandling hos patienter, der er symptomatisk med SMZL. Denne beslutning er baseret på ældre retrospektive studier [6, 12], hvor splenektomi blev brugt ikke kun som en terapeutisk modalitet, men også diagnostisk, idet mikroskopisk undersøgelse af milten var den mest pålidelige metode, når diagnosen SMZL skulle stilles [7, 11]. Mulligan et al [12] splenektomerede 20 patienter med SMZL. Nitten af patienterne responderede, og hos 17 (89%) var responsen bevaret efter en median opfølgningstid på fire år. Splenektomi har vist en responsrate (overall response rate (ORR)) på 75-100% [6, 9], men der er også noteret en tilbagefaldsrate på ca. 30% efter en median opfølgningstid på ca. 3 år [6, 7, 9]. Det er dog også beskrevet, at splenektomi kan ændre infiltrationsmønsteret og øge tumorbyrden i knoglemarven hos patienter med SMZL [12, 13]. Spenektomi er forbundet med risici, og specielt ældre patienter kan være uegnede til splenektomi.
Splenisk bestråling
Denne modalitet er ikke undersøgt i samme udstrækning som splenektomi. Troussard et al [6] anvendte splenisk bestråling hos ni patienter med SMZL og noterede en ORR på 100%, men en relapsrate på 43% efter en median opfølgningstid på 40 måneder, mens Parry-Jones et al [8] afprøvede denne modalitet hos ni patienter, hvoraf fem (55%) havde behov for yderligere behandling. El Weshi et al [14] observerede god effekt af lavdosis splenisk strålebehandling (ca. 4 Gy) hos fire patienter, som responderede med regression af splenomegali eller normalisering af hæmatologi, men en af dem fik tilbagefald efter 28 måneder.
Anti-hepatitis C-virus-behandling
I flere undersøgelser har man påvist en sammenhæng mellem hepatitis C-virus (HCV)-infektion og B-celle-non-Hodgkin-lymfom både i form af højere prævalens af HCV-infektion hos patienter med non-Hodgkin-lymfomer [15] og i form af en høj relativ risiko for udvikling af non-Hodgkin-lymfom hos HCV-positive patienter [16]. Specielt for SMZL er det beskrevet, at knap 20% af patienterne med SMZL samtidig havde en positiv HCV-serologi [11, 12]. HCV-infektion eller kryoglobulinæmi er også observeret inden påvisning af SMZL hos nogle patienter [17]. Det må dog bemærkes, at disse data kommer fra sydeuropæiske lande, hvor prævalensen af HCV-infektioner som regel er højere.
Hermine et al [18] beskrev både virolog isk og hæmatologisk respons hos HCV-positive patienter ved behandling med interferon (INF)-α ± ribavirin, hvorimod den samme behandling ingen hæmatologisk effekt havde hos HCV-negative patienter med SMZL. Saadoun et al [17] behandlede 18 patienter med SMZL med IFNα ± ribavirin, og alle opnåede både virologisk og hæmatologisk respons. I andre mindre studier har man påvist lignende resultater.
Kemoterapi
Både enkeltstofskemoterapi og kombinationskemoterapi er beskrevet anvendt hos patienter med SMZL.
Chlorambucil
Iannitto et al [10] behandlede 17 patienter med chlorambucil. ORR var 65%, men ingen opnåede komplet remission (CR). Parry-Jones et al [8] beskriver også anvendelse af chlorambucil, men der foreligger ikke detaljerede opgørelser.
Purinanaloger
Fludarabin er en purinanalog med dokumenteret effekt ved flere lymfoproliferative sygdomme. De første resultater for behandling af patienter med SMZL kommer fra en kasuistik med fem patienter i alt. Bolam et al [19] anvendte monoterapi med fludarabin hos fire patienter med SMZL. Patienterne havde enten fået relaps efter splenektomi, eller sygdommen var resistent for chlorambucil. Alle opnåede CR og med langvarig remission. Lefrère et al [20] brugte fludarabin hos ti patienter med SMZL og noterede en ORR på 100%, men også en høj relapssrate på 70% efter ca. seks års opfølgning.
I et prospektivt, ikkerandomiseret studie blev 16 patienter behandlet med pentostatin som førstelinjebehandling. Elleve patienter (68%) responderede på behandlingen, men efter en median opfølgningstid på 35 måneder havde syv (63%) af dem, der responderede, fået relaps og blev behandlet med splenektomi [21].
I to studier har man anvendt cladribin som monoterapi til behandling af SMZL, med modstridende resultater. Riccioni et al [22] behandlede ti patienter med cladribin. Otte (80%) responderede - seks af dem med CR. Relapsraten var på 38% efter en ret kort opfølgningsperiode på ni måneder [23]. Lefrère et al [24] anvendte den samme behandling hos syv patienter, hvoraf fem responderede, dog kun to med CR. Relapsraten var på 80% efter en median opfølgningstid på tre måneder.
Andre regimer
Troussard et al [6] har i deres studie anvendt både monoterapi og kombinationskemoterapi hos 19 patienter og fandt en ORR på 52% og en Relapsrate på 60% efter en opfølgningsperiode på ca. tre år. Ingen opnåede CR [6]. I et studie af Thieblemont et al [9] blev der beskrevet 13 patienter, der blev behandlet med monoterapi eller kombinationskemoterapi. ORR blev fundet at være 100%, og relapssraten var 46%. Iannitto et al . [10] anvendte kombinationskemoterapi hos seks patienter, hos hvem ORR blev på 83%, mens Mulligan et al [12] har noteret en ORR på 36%.
Rituximab
De maligne celler i SMZL er positive for CD20, hvilket gør immunterapi med det monoklonale anti-CD20-antistof rituximab velegnet. Det først publicerede studie, hvor man brugte rituximab som monoterapi hos 11 patienter med SMZL (ni af dem var tidligere blevet behandlet med kemoterapi), viste en ORR på 91% og en relapsrate på 36% med en median opfølgningstid på 58 måneder [25, 26]. Tsimberidou et al [27] anvendte rituximabmonoterapi hos 25 patienter. ORR var 88%, og relapsraten var 23% efter en median opfølgningstid på ca. tre år. Rituximab enten alene eller kombineret med kemoterapi resulterede i en statistisk signifikant større overlevelsesrate (p = 0,047) end kemoterapi alene [27]. Kalpadakis et al behandlede 16 patienter med rituximabmonoterapi; 12 af patienterne fik desuden vedligeholdelsesbehandling og havde en ORR på 100% og en relapsrate på 18% efter en opfølgningstid på ca. 25 måneder [28].
Immunkemoterapi med rituximab er også beskrevet af Arcaini et al [29] og Cervetti et al [30]. Tilføjelse af rituximab resulterede i en højere CRR (62,5% vs. 21,4%; p = 0,004) og en fireårig tid til progression på 83,4% vs. 52,4% (p = 0,04) end behandling med cladribin alene [30]. Tsimberidou et al [27] anvendte immunkemoterapi (fortrinsvis R-FC: rituximab + fludarabin + cyclophosphamid) hos seks patienter, hvoraf fem responderede - tre med CR.
KONKLUSION
De fremlagte data om behandling af SMZL bekræfter den manglende evidens på området. Antallet af patienter med SMZL er meget beskedent, hvorfor der ikke findes gode randomiserede prospektive studier. Der er en vis grad af evidens for, at HCV-positive patienter med SMZL kan opnå hæmatologisk respons ved behandling med INF og ribavirin. Derfor skal HCV-serologi være en del af den diagnostiske udredning hos patienter med SMZL. Splenektomi er tradi-tionelt førstelinjebehandling ved symptomgivende sygdom. Splenektomi har vist bedre OS, end kemoterapi har [6, 8], men dette skal tolkes forsigtigt, eftersom der har været en tendens til at behandle patienter med mere aggressiv sygdom med kemoterapi [1, 7]. Det monoklonale antistof mod CD20 (rituximab) som monoterapi er en ret ny og lovende behandling, som kunne være et alternativ til splenektomi. Splenektomi over for rituximab er ikke undersøgt prospektivt, men i et retrospektivt studie fandt man ingen statistisk signifikant forskel (p = 0,56) på failure free survival mellem splenektomi og rituximabmonoterapi, selvom rituximab var bedre end splenektomi (p < 0,001) til normalisering af lymfocytter og leukocytter. Desuden er rituximab den eneste behandlingsmodalitet, der har resulteret i remission på molekylært niveau [28, 30], men den kliniske betydning af komplet molekylær remission er ukendt. Rituximab i kombination med forskellige typer kemoterapi er beskrevet anvendt, men kun med et begrænset antal patienter og ikke i randomiserede prospektive studier. Som for andre lavmaligne lymfomer må det forventes, at kombineret kemoimmunterapi resulterer i øget ORR.
Det eneste forsøg på en form for retningslinjer er udarbejdet af en stor gruppe [23] af eksperter på området, og anbefalingerne er wait and watch- strategi hos de asymptomatiske patienter og anti-HCV-behandling hos de HCV-positive patienter med SMZL. De symptomatiske patienter kan behandles enten med splenektomi eller med kemoterapi, men evidensen på dette område er begrænset [23]. Der mangler randomiserede studier med patienter med SMZL, hvilket dog er vanskeligt at gennemføre på grund af den lave incidens.
Summary:
Splenic marginal zone lymphoma
Ugeskr Læger 2012;174(40):2383-2386
Splenic marginal zone lymphoma (SMZL) with or without villous lymphocytes is a low-grade malignant lymphoma, which primarily involves the spleen, the bone marrow and the blood. Even though the prognosis of the disease is good and there is a long overall survival, about two thirds of the patients will require treatment and in 10% of the patients the lymphoma will transform into a high-grade malignant lymphoma. The treat-ment of SMZL remains empirical, since there is lack of large, prospective studies. Without such studies, the best treatment modality cannot be established.
KORRESPONDANCE: Konstantinos Dimopoulos, Hæmatologisk Afdeling, Herlev Hospital, Herlev Ringvej 75, 2730 Herlev. E-mail: stamatiskostas@msn.com
ANTAGET: 9. maj 2012
FØRST PÅ NETTET: 9. juli 2012
INTERESSEKONFLIKTER: Forfatternes ICMJE-formularer er tilgængelige sammen med artiklen på Ugeskriftet.dk
<ol class="Litt-list">
<li>Franco V, Florena AM, Iannitto E. Splenic marginal zone lymphoma. Blood 2003;101:2464-72.</li>
<li>Dansk Lymfomgruppe. Årsrapport 2009. www.lymphoma.dk</li>
<li>Melo JV, Robinson DS, Gregory C et al. Splenic B cell lymphoma with "villous" lymphocytes in the peripheral blood: a disorder distinct from hairy cell leuk-emia. Leukemia 1987;1:294-8.</li>
<li>Schmid C, Kirkham N, Diss T et al. Splenic marginal zone cell lymphoma. Am J Surg Pathol 1992;16:455-66.</li>
<li>Swerdlow SH, Campo E, Harris NL et al. World Health Organization classification of tumours of haematopoietic and lymphoid tissues. Lyon: IARC Press, 2008.</li>
<li>Troussard X, Valensi F, Duchayne E et al. Splenic lymphoma with villous lymphocytes: clinical presentation, biology and prognostic factors in a series of 100 patients. Br J Haematol 1996;93:731-6.</li>
<li>Chacón JI, Mollejo M, Munoz E et al. Splenic marginal zone lymphoma: clinical characteristics and prognostic factors in a series of 60 patients. Blood 2002;100:1648-54.</li>
<li>Parry-Jones N, Matutes E, Gruszka-Westwood AM et al. Prognostic features of splenic lymphoma with villous lymphocytes: a report on 129 patients. Br J Haematol 2003;120:759-64.</li>
<li>Thieblemont C, Felman P, Berger F et al. Treatment of splenic marginal zone B-cell lymphoma: an analysis of 81 patients. Clin Lymphoma 2002;3:41-7.</li>
<li>Iannitto E, Ambrosetti A, Ammatuna E et al. Splenic marginal zone lymphoma with or without villous lymphocytes. Cancer 2004;101:2050-7.</li>
<li>Arcaini L, Lazzarino M, Colombo N et al. Splenic marginal zone lymphoma: a prognostic model for clinical use. Blood 2006;107:4643-9.</li>
<li>Mulligan SP, Matutes E, Dearden C et al. Splenic lymphoma with villous lymphocytes: natural history and response to therapy in 50 cases. Br J Haematol 1991;78:206-9.</li>
<li>Franco V, Florena AM, Stella M et al. Splenectomy influences bone marrow infiltration in patients with splenic marginal zone cell lymphoma with or without villous lymphocytes. Cancer 2001;91:294-301.</li>
<li>El Weshi A, Ribrag V, Girinski T et al. Low and medium dose spleen radiation therapy are able to induce long-term responses in splenic lymphoma with villous lymphocytes. Br J Haematol 1998;103:1212-3.</li>
<li>Gisbert JP, García-Buey L, Pajares JM et al. Prevalence of hepatitis C virus infection in B-cell non-Hodgkin's lymphoma: systematic review and meta-analysis. Gastroenterology 2003;125:1723-32.</li>
<li>Dal Maso L, Franceschi S. Hepatitis C virus and risk of lymphoma and other lymphoid neoplasms: a meta-analysis of epidemiologic studies. Cancer Epidemiol Biomarkers Prev 2006;15:2078-85.</li>
<li>Saadoun D, Suarez F, Lefrere F et al. Splenic lymphoma with villous lymphocytes, associated with type II cryoglobulinemia and HCV infection: a new entity? Blood 2005;105:74-6.</li>
<li>Hermine O, Lefrère F, Bronowicki JP et al. Regression of splenic lymphoma with villous lymphocytes after treatment of hepatitis C virus infection. N Engl J Med 2002;347:89.</li>
<li>Bolam S, Orchard J, Oscier D. Fludarabine is effective in the treatment of splenic lymphoma with villous lymphocytes. Br J Haematol 1997;99:158-61.</li>
<li>Lefrère F, Lévy V, François S et al. Fludarabine therapy in patients with splenic lymphoma with villous lymphocytes: an update. Leukemia 2004;18:1924-5.</li>
<li>Iannitto E, Minardi V, Calvaruso G et al. Deoxycoformycin (pentostatin) in the treatment of splenic marginal zone lymphoma (SMZL) with or without villous lymphocytes. Eur J Haematol 2005;75:130-5.</li>
<li>Riccioni R, Caracciolo F, Galimberti S et al. Low dose 2-CdA schedule activity in splenic marginal zone lymphomas. Hematol Oncol 2003;21:163-8.</li>
<li>Matutes E, Oscier D, Montalban C et al. Splenic marginal zone lymphoma proposals for a revision of diagnostic, staging and therapeutic criteria. Leukemia 2008;22:487-95.</li>
<li>Lefrère F, Hermine O, François S et al. Lack of efficacy of 2-chlorodeoxyadenoside in the treatment of splenic lymphoma with villous lymphocytes. Leuk Lymphoma 2000;40:113-7.</li>
<li>Bennett M, Sharma K, Yegena S et al. Rituximab monotherapy for splenic marginal zone lymphoma. Haematologica 2005;90:856-8.</li>
<li>Bennett M, Yegena S, Dave HP et al. Rituximab monotherapy is highly effective in splenic marginal zone lymphoma. Hematol Oncol 2008;26:114.</li>
<li>Tsimberidou AM, Catovsky D, Schlette E et al. Outcomes in patients with splenic marginal zone lymphoma and marginal zone lymphoma treated with rituximab with or without chemotherapy or chemotherapy alone. Cancer 2006;107:125-35.</li>
<li>Kalpadakis C, Pangalis GA, Dimopoulou MN et al. Rituximab monotherapy is highly effective in splenic marginal zone lymphoma. Hematol Oncol 2007;25:127-31.</li>
<li>Arcaini L, Orlandi E, Scotti M et al. Combination of rituximab, cyclophosphamide, and vincristine induces complete hematologic remission of splenic marginal zone lymphoma. Clin Lymphoma 2004;4:250-2.</li>
<li>Cervetti G, Galimberti S, Sordi E et al. Significant efficacy of 2-CdA with or without rituximab in the treatment of splenic marginal zone lymphoma (SMZL). Ann Oncol 2010;21:851-4.</li>
</ol>